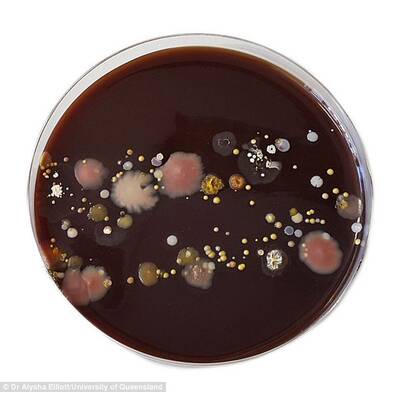
Hände waschen
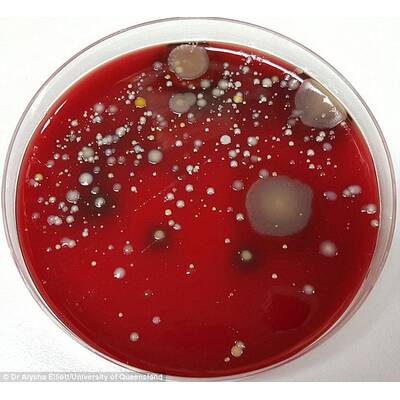
Hände waschen
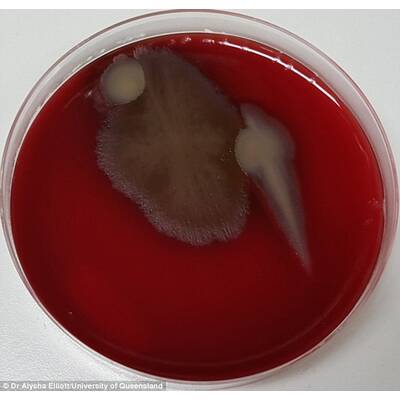
Hände waschen
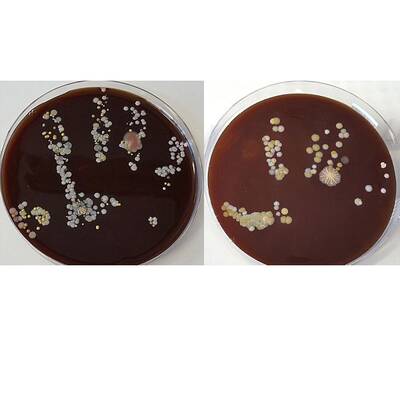
Hände waschen

Die Universität von Queensland nahm Bakterien im Büro genaustens unter die Lupe.
Nicht die Toilette,Türgriffe und auch nicht Schreibtische sind voller Bakterien - sie sind sogar die saubersten Flächen, die man in einem Büro finden kann. Die wahren Keimschleuder in unserer täglichen Umgebung sind vor allem Telefonhörer, Smartphones, Küchenbänke und PC-Tastaturen.
Die Universität von Queensland erforschte im Rahmen einer Untersuchung wie viele Bakterien sich auf Flächen tummeln, mit denen wir täglich in Berührung kommen und zeigte die Resultate der verschiedenen Abstriche in Bildern. Diese machen nicht nur deutlich wie schockierend viele Bakterien tatsächlich auf bestimmten Dingen zu finden waren, sondern auch wie ernst wir das regelmäßige Händewaschen nehmen sollten.
Wenn Sie in einem Büro arbeiten, dann werden Sie nach diesen Bildern wohl öfter einmal Lust darauf haben, denn die Abstriche zeigten auch, dass Desinfektionsgels nur wenig Effekt haben. Nur nach der Reinigung der Hände mit Wasser und Seife sinkte die Bakterienanzahl. Das Händewaschen beseitigt nicht nur angesammelte Bakterien, es beugt auch ernsthaften krankheiten wie Influenza und Lungenentzündungen vor.
Bakterien im Büro
© Getty
Der Abstrich eines Menschen, der zuvor seinen Smartphone-Bildschirm angegriffen hatte - hier waren die meisten Bakterien zu finden.
© Getty
Die Küchenbank war einer der schmutzigsten Plätze im Büro.
© Getty
Auch der Telefonhörer ist eine Bakterienschleuder, das Bild zeigt die Bakterien, nachdem eine Person den Telefonhörer berührte.
© Getty
Das linke Bild zeigt den Abstrich, nachdem sich eine Person die Hände mit Desinfektionsgel reinigte, rechts der Abstrich nachdem sie sich die Hände mit Wassr und Seife gewaschen hatte - dieser zeigte deutlich weniger Bakterien.
Und das sind die 10 dreckigsten Dinge und Orte in Ihrem Haushalt:
Die 10 dreckigsten Orte im Haushalt
1/10
1. Küchenschwamm
Ein wahres Paradies für Keime ist der feuchte Küchenschwamm. Richtig eklig: Bei Untersuchungen wurden über 300 Millionen Keime allein in einem Gramm eines Spülschwammes gefunden. Als Faustregel gilt: Wenn man etwas aufgewischt hat, dass man nicht im Mund haben will wirft man den Schwamm am besten weg! Geschirrtücher sollten bei 60 Grad in der Waschmaschine gewaschen werden, damit Keime und Bakterien abgetötet werden können.
2. Spüle
In der Spüle landet so ziemlich alles: Essensreste, Dreck, Bakterien von Dingen, die wir abwaschen,... Kein Wunder, dass in Spülbecken jede Menge Keime und Bakterien gefunden werden. Waschen Sie die Spüle am besten zwei Mal die Woche mit einem Desinfektionsreiniger ab.
3. Zahnbürstenhalter
Wo bewahren Sie Ihre Zahnbürste auf? Egal ob in einem Bürstenhalter oder in einem Becher - hier sammelt sich jede Menge Dreck, der von der Bürste tropft. Wissenschaftler konnten hier Streptokokken und Kolibakterien nachweisen. Reinigen Sie den Zahnbürstenhalter zwei Mal die Woche in der Spülmaschine und wechseln Sie Ihre Zahnbürste regelmäßig.
4. Geschirr von Haustieren
Wenn Sie Ihr Haustier füttern, bleiben Reste oft stundenlang im Napf zurück. Das begünstigt die Ansammlung von Keimen, die das Tier krank machen können. Tipp: Das Essgeschirr von Tieren sollte jeden Tag gespült werden.
5. Kaffeemaschine
Bakterienfalle Kaffeemaschine. Im Wassertank tummeln sich jede Menge Schimmelpilze. Wischen Sie den Wassertank mit einem Papiertuch aus und reinigen Sie die Maschine einmal die Woche mit Essig.
6. Wasserhähne
An den Wasserhähnen von Küche und Bad, tummeln sich jede Menge Keime. Ist ja auch kein Wunder: Wir drehen das Wasser mit schmutzigen Hände auf und auch beim Putzen wird der Wasserhahn gerne mal vergessen. Beim nächsten Putzen also den Wasserhahn mitreinigen!
7. Haustier-Spielzeug
Auf dem Spielzeug Ihres Haustieres findet man Kolibakterien, Hefe- und Schimmelpilze sowie Staphylokokken. Reinigen: Spielzeug aus Gummi und Plastik können Sie einmal die Woche mit heißem Wasser und Spülmittel reinigen. Spielzeug aus Stoff sollte in der Waschmaschine gereinigt werden.
8. Arbeitsplatten
Auf der Arbeitsplatte der Küche wird so gut wie alles abgelegt. Auf Arbeitsflächen fanden Forscher deswegen Kolibakterien und andere Keime. Reinigen Sie die komplette Arbeitsfläche einmal am Tag mit heißem Wasser und Spülmittel.
9. Knöpfe am Herd
An den Herd-Reglern bleiben jede Menge Bakterien haften. Mit heißem Wasser und Spülmittel regelmäßig reinigen!
10. Schneidbretter
Schneidbrett und Messer sind eine weitere Keimquelle. Denn darüber können sich Keime auf andere Lebensmittel übertragen. Waschen Sie diese Küchenutensillien sofort nach dem Kontakt mit Fleisch, Fisch oder rohen Eiern mit heißem Wasser ab. Noroviren können mehrere Tage auf Gegenständen überleben. Auch die Arbeitsplatte, Wasserhahn und Spüle sollten täglich gereinigt werden.